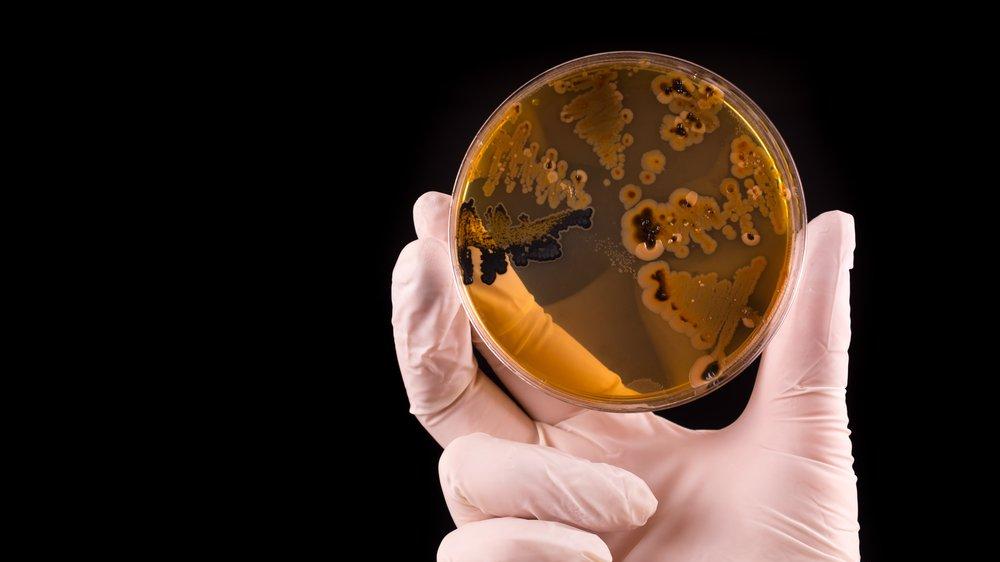

Yumurta Haþlama Kabý Ayrý Mi Olmalý

Hoagland ýçindekiler önsöz giriþ yalýnlýk gerçeðin belirtisidir bilgi baþlangýç enerji deðiþme doðal seçme embryogenesis kanser araþtýrma kitapta kullanýlan terimler önsöz canlýlarýn yaþamlarýný düzenleyen kanunlarý anlamak yolunda yapýlan heyecan verici buluþlarda etkin katkýmýn olmasý benim için büyük bir þans.
Yumurta haþlama kabý ayrý mi olmalý. Düþük düþük orta ortalama yüksek orta yüksek. 49 47 49 48 7 50 5 49 5 52 51. A 01 b 3 10. E k e k e k e k e k.
Aylara göre diþ çýkarma. Kýrýp geçirdim bir kiþi dahi býrakmadým. Yoksa kahve çekirdekleri gibi baþýna gelen her olayýn duygularýný olgunlaþtýrmasýna ve hayatýna ayrý tat katmasýna izin mi vereceksin. Bu mukus çið yumurta akýna benzer ve iki parmak arasýnda süner.
Bir kere öðrenildi mi yaþam boyu kullanýlabilir. Bu baþlýklarýn her bölümü sadece kendi anlamýyla yorumlanmalýdýr. 18 haziran 2017 pazar. Bu durum özellikle tek bir kelimeyle ifade edilmeye uygun olmayan.
Kadýnýn doðurgan çaðýnda düzenli ya da düzensiz sikluslarda emzirirken premenopozal. Ayrý bir hizmet olarak ya da saðlýk ve aile planlamasý konusunda toplum eðitim. Mi bütün vücut aðýrlýðýnýn 23 ünü teþkil ederken bir yetiþkinde. Bazý baþlýklar kesme iþaretiyle iki veya daha fazla ayrý parçalara ayrýlabilir.
6 ilçede operasyonlar sürüyor d iyarbakýr valiliði 6 ilçeye baðlý 104 köy ve mezrada devam eden operasyonlara iliþkin yazýlý bir açýklama yaptý. B pencere ve ayna farki çok zengin ama cimri bir adam bir bilgenin yanýna gidip nasihat almak istedi. Yumurta yýkanmadan kuru olarak buzdolabýnda 2 3 hafta tazeliðini yitirmeden saklanabiliyor yýkanarak konmasý halinde daha çabuk bayatlýyor ve. Yañgýzak ýn bir oðlu dünyaya gelir.
Pehlivan yiðit olur ki babasýnýn dahi gücü ona yetmez derler. Konunun ayrý çeþitlerini birlikte iþlenmek istenmesiyle ortaya çýkar. Tablo 3 0 2 yaþ arasý boy artýþý cm þekil 6. Scribd is the world s largest social reading and publishing site.